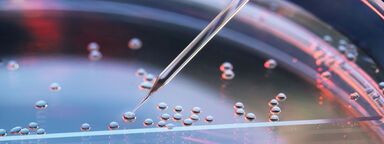
A nuclear transfer being carried out on several embryonic stem cells for cloning

Centre for Stem Cell Biology
We are a centre of excellence for pioneering stem cell research, undertaking fundamental and applied research on the biology of pluripotent stem cells with the aim to develop cell therapies for regenerative medicine.
Sponsors and partnerships
The Centre for Stem Cell Biology has a number of generous sponsors and partners that we collaborate with in many projects, please see below and click the individual names for more information.
Stem cell FAQs
We run a dynamic programme of training for stem cell biologists, as well as offering a visiting scientist programme for short and medium-term visits.
Contact us
If you have any questions or enquiries regarding the Centre for Stem Cell Biology, please feel free to contact us.







